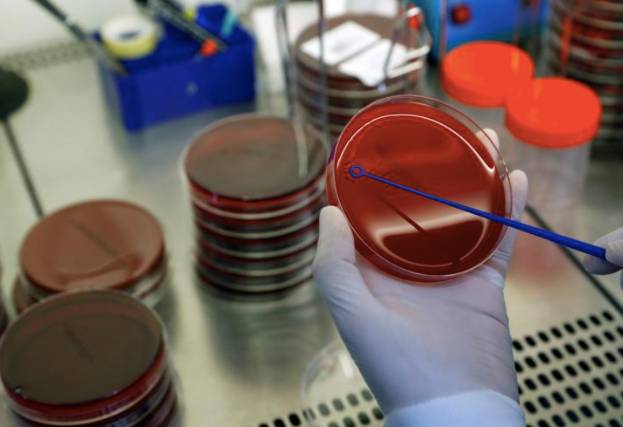
昨天新加坡境外輸入15例!專家:澳洲和越南遊客可能不會來

昨日新增病例19例,總病例數達57784。
其中15起爲境外輸入病例,1起社區病例,3起爲客工病例。
15起境外輸入病例,其中主要從印度輸入,其余輸入型確診病例曾到訪的國家包括馬來西亞、印度尼西亞、菲律賓和法國。
其中,有4起病例爲船員,在上個月23日從馬來西亞抵達新加坡後並未上岸,確診後直接被送往醫院。
其余病例均在抵達新加坡後,收到了爲期14天的居家通告(SHN)。
這也是新加坡輸入型病例數首次超越客工宿舍確診病例數。
1起社區病例,是一名54歲的女性永久居民,她同早前確診病例有關聯。
以上來源:MOH
3起客工病例,其中有1例是之前確診病例的密切接觸者,已經被提前隔離,他們在隔離期間被確診。
其余2例是當局例行每兩周對客工宿舍進行檢測時被發現的。
來源:mothership
與此同時,衛生部已經將雙溪加株環道(Sungei Kadut Loop)8號的客工宿舍從感染群中除名,因爲該宿舍在過去28天內未出現與其有關的新病例出現。
昨日無新增感染群,但有兩個現有感染群出現新病例。
昨日共有24人出院,仍有44人住院治療,201人在社區接受隔離或護理,死亡人數維持在27人。
歐美新一波疫情爆發
據實時信息數據更新網站Worldometers的統計數據顯示,截至北京時間9月30日13時55分,全球新冠肺炎累計確診病例數超3385萬例,計死亡超101萬例。
全球疫情持續擴散,美國、英國、法國和西班牙等多國都出現了疫情嚴重反彈。
美國:單日新增確診病例逾4.5萬例,福奇稱隨著天氣變冷,美國疫情“處境不佳”。在截至9月27日的一周中,全美範圍內的病例增長了近9%,平均日增確診病例超過44300例。
以上來源:BBC
全美26個州,確診病例平均增長了5%甚至更多。蒙大拿州、南達科他州、猶他州、威斯康星州和懷俄明州,確診病例數均創新高。
英國:一日新增7143例,創本國曆史新高。
當地時間9月29日,據英國天空新聞報道,過去的24小時內英國新增新冠病毒感染病例7143例,創曆史新高,另有71人死亡,這一數字遠高于前一日死亡病例數。
以上來源:fb
英國衛生大臣馬修·漢考克宣布爲避免新冠疫情的進一步擴散 英國政府將從30日開始對英格蘭東北部部分地區實施社交封鎖限制,涉及人口超過200萬。
來源:fb
法國:巴黎感染率突破警戒線,將評估是否提高警報水平。當地時間29日,巴黎新冠感染率突破官方設定的最高警戒阈值(每10萬居民中有250名感染者)。
巴黎醫院的新冠肺炎患者在重症監護室中的比例已經達到30%。
澳洲越南遊客來新加坡,困難多!
新加坡將從下周四(10月8日)起允許來自澳大利亞(不包括維多利亞州)的和越南遊客入。
新加坡交通部長Ong Ye Kung指出,之所以決定取消這兩個國家的邊境限制,是因爲澳大利亞和越南已經成功的控制了Covid-19疫情的蔓延,病毒從這兩國輸入新加坡的風險很低。
以上來源:鳳凰
從10月1日中午12時起,在上述區域的旅客可以申請航空通行證(Air Travel Pass),並從10月8日起進入新加坡。。
政策下來了,可是實施落地又是一大難題。許多在澳洲和越南的遊客可能不願意前往新加坡,因爲他們回國後仍需接受檢疫和隔離。
目前,澳大利亞政府仍然采取著嚴格的旅行限制措施,任何想出國的人必須獲得內政部的批准。
與此同時,澳大利亞還要求所有從國外抵達的旅客都要進行14天的隔離,費用自理。如新南威爾士州,從國外抵達本地的人必須支付3000美元(2940新元)的檢疫隔離費用。
越南的政策是已出國的越南人需從排隊入境起就被單獨隔離,入境後還要進行14天的檢疫隔離。
以上來源:路透社
可以看出,雖然新加坡開放邊境,越南澳洲的遊客也不會這麽快的到來,新加坡航空業的複蘇還需要時間,對中國大門的打開或許是未來的轉機。
專家:新冠疫苗無法讓疫情在今年底結束
新冠疫苗被廣泛視爲是能夠終結這場大流行病的神藥。
但近日,由科學期刊《皇家學會》召集的一組研究人員發布報告,並指出即使有效的新冠疫苗問世,今年底疫情也無法徹底結束,明年春天大家的生活也不會恢複正常。
雖然目前全球科學家正以史無前例的超趕速度研制超過200種潛在的冠病疫苗。
但是,這些疫苗的實際有效率很難保證。
同時一批疫苗的生産、分配及最後大規模的接種也會耗時很久。
以上來源:twitter
因此全球的防疫限制措施還是要以“逐步放寬”的方式進行,並表示疫苗的問世很難能讓大家的生活在明年春天就恢複正常。